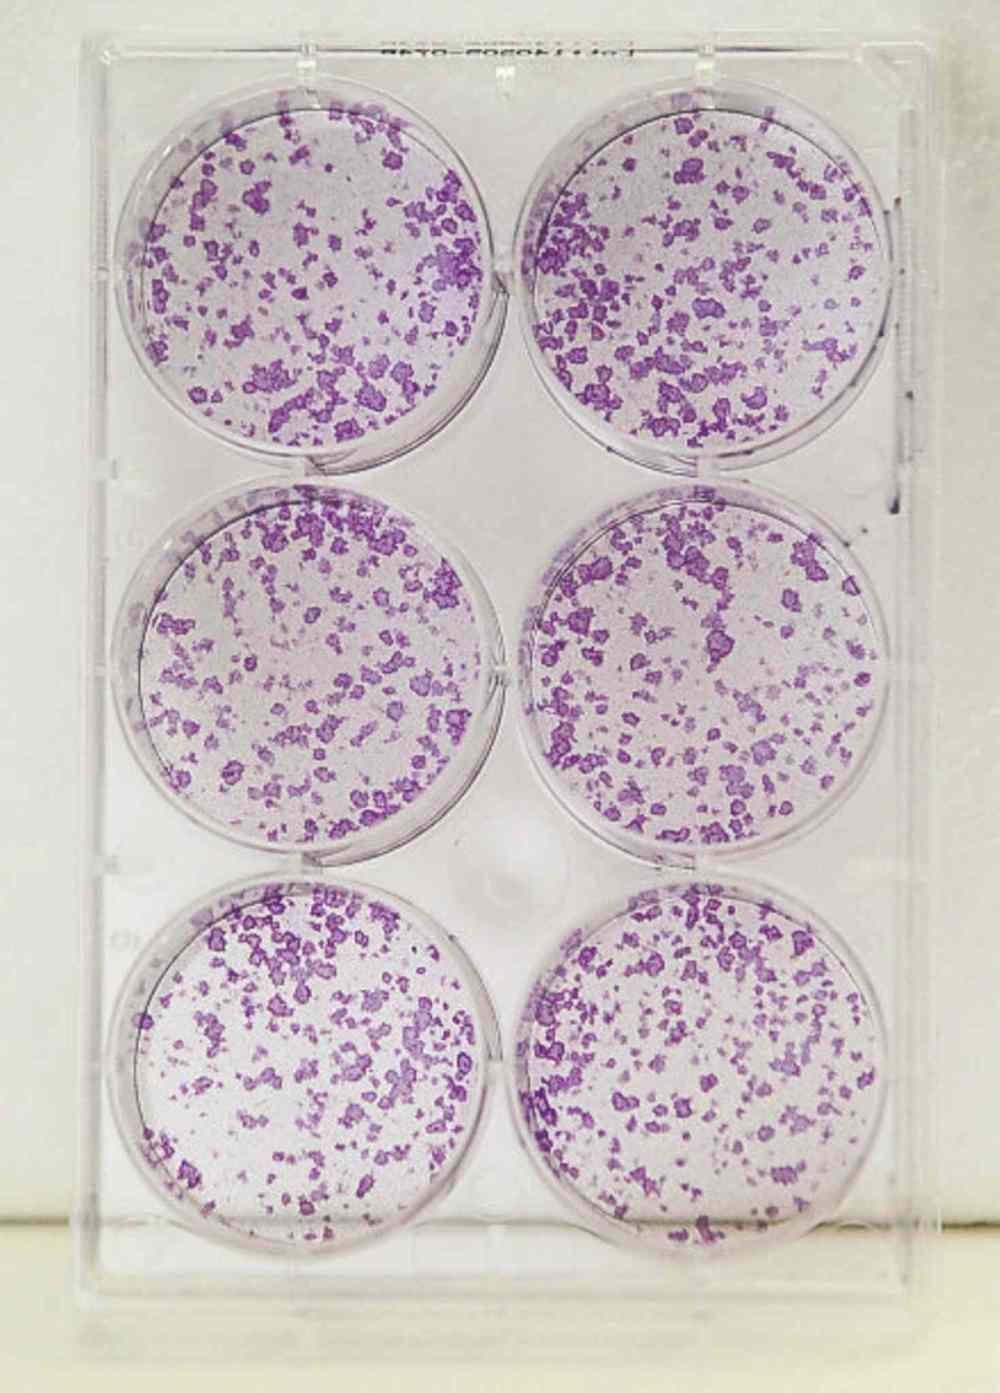

Deciphering cancer’s code
Work by local scientists could lead to breast-cancer prediction and prevention
Advertisement
Read this article for free:
or
Already have an account? Log in here »
To continue reading, please subscribe:
Monthly Digital Subscription
$1 per week for 24 weeks*
- Enjoy unlimited reading on winnipegfreepress.com
- Read the E-Edition, our digital replica newspaper
- Access News Break, our award-winning app
- Play interactive puzzles
*Billed as $4.00 plus GST every four weeks. After 24 weeks, price increases to the regular rate of $19.95 plus GST every four weeks. Offer available to new and qualified returning subscribers only. Cancel any time.
Monthly Digital Subscription
$4.99/week*
- Enjoy unlimited reading on winnipegfreepress.com
- Read the E-Edition, our digital replica newspaper
- Access News Break, our award-winning app
- Play interactive puzzles
*Billed as $19.95 plus GST every four weeks. Cancel any time.
To continue reading, please subscribe:
Add Free Press access to your Brandon Sun subscription for only an additional
$1 for the first 4 weeks*
*Your next subscription payment will increase by $1.00 and you will be charged $16.99 plus GST for four weeks. After four weeks, your payment will increase to $23.99 plus GST every four weeks.
Read unlimited articles for free today:
or
Already have an account? Log in here »
Hey there, time traveller!
This article was published 15/06/2015 (3923 days ago), so information in it may no longer be current.
A team of Winnipeg researchers is the first in the world to discover the mysterious language shared between estrogen and healthy breast cells.
The findings — recently published in the peer-reviewed medical journal, Endocrine-Related Cancer — could lead to early prediction of estrogen-fuelled breast cancer before it ever happens, says Afshin Raouf, lead author of the study.
It took the six authors of the study five years to complete their research, says Raouf, who also works as an assistant professor of immunology at the University of Manitoba.

He is cautiously optimistic the medical community will be able to use his team’s findings to help patients prevent the onset of breast cancer sooner rather than later.
Applying scientific research to real life, however, takes time.
“I don’t want it to take a decade. It took us five years to get here. And I am pleased with the progress that we have made,” says Raouf. “Some of the difficult parts are over. But… if it was easy it would have been done already.”
He estimates that his work could be used to assess and prevent estrogen-induced breast cancer risk “within the next five to 10 years.”
Raouf says more than 75 per cent of all breast cancer cases are fuelled by estrogen, a hormone essential to human development, particularly to women. He says scientists have a clear understanding about how estrogen communicates with cancerous breast cells.
But he says scientists have never understood the messages that estrogen relays to healthy breast cells. This set of instructions is key in determining early changes in breast tissue before cancer appears, says Raouf.
“If you don’t know how these cells behave and should behave, how could you detect early changes, early signs that things are going wrong? So we could never assess… a woman’s risk of developing estrogen-responsive cancers because we didn’t know what’s abnormal.”
Why the difficulty in studying healthy breast tissue? There are two reasons, says Raouf. Finding estrogen-responsive cells in human breast tissue “is to find the needle in the haystack.” It’s also much harder to keep healthy breast tissue alive in a lab setting than cancerous breast tissue, since healthy breast tissue requires a specific set of nutrients to thrive.
“So it ends up that they’re a lot more finicky, in that they care a lot more about what kind of food sources, growth factors and hormones are present,” says Raouf, noting that he and his team came up with the perfect combination to keep healthy breast-cell specimens thriving.
The healthy cell specimens came from womens’ breast-reduction surgery tissue. The cancerous tissue was several decades old — from a research bank in the United States, says Raouf, a senior scientist at the Manitoba Institute for Cell Biology.
Breast cancer is the second leading cause of cancer-related deaths in Canadian women.
It’s predicted that 25,000 women will be diagnosed with breast cancer in 2015, says the Canadian Cancer Society. (Most cases are caused by estrogen rather than genetic mutations of the sort that put people such as actress Angelina Jolie at risk for the disease. She underwent a double mastectomy in 2013 as a preventative measure).
Raouf says one in nine women will be diagnosed with breast cancer. “To me, that number is just too high,” he says.
The research scientist was recruited from Vancouver six years ago because of his ability to isolate and extract healthy breast cells — his area of specialty. He says a conversation six years ago with colleague Leigh Murphy, a co-author of the study and a leading authority on estrogen-dependent breast cancer, sparked his latest publication.
“We were speaking about how estrogen affects cells functions… and she told me that there is a gap in knowledge about that.”
Endocrine-Related Cancer journal editor Dr. Charis Eng — also a director with the renowned Cleveland Clinic in Ohio — confirms that Raouf’s study is a first-of-its-kind breakthrough that could help prevent breast cancer in patients.
“Uncovering processes in healthy tissue will lead to future strategies of treating or preventing breast pathology,” Eng wrote in an email to the Winnipeg Free Press.

Raouf says his team plans to continue its studies. But he also hopes that other breast-cancer researchers around the world take note of his work — and expand on it.
“We all have different angles. We all have a unique… background that helps us interpret the information differently,” he says.
“Combining it all together will hopefully accelerate this faster.”
Have an interesting story idea you’d like Shamona to write about? Contact her at shamona.harnett@freepress.mb.ca.
History
Updated on Monday, June 15, 2015 8:52 AM CDT: Replaces photo, fixes cutlines

